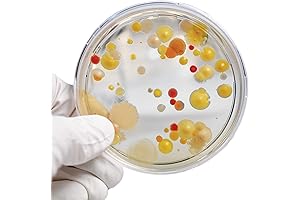
Liquid Worms Science Kit: Steve Spangler's Growing Bacteria Experiment Kit

· science kits and amp toys · 14 min read
Best Liquid Worms Science Kit For Kids: A Comprehensive Guide
Immerse your child in a world of scientific discovery with the best liquid worms science kit. Our comprehensive guide showcases top-rated kits, empowering kids to explore the fascinating biology of worms in a fun and engaging way.
Are you seeking to foster your child's scientific curiosity? Look no further than a liquid worms science kit. These kits provide a hands-on, interactive way for kids to observe and learn about the captivating world of worms. Join us as we delve into the best liquid worms science kits available. Each kit is meticulously designed to engage young minds, cultivate a passion for science, and provide an unforgettable learning experience.
Overview

PROS
- Exciting and engaging hands-on activity for kids.
- Teaches the principles of polymers and chemistry in a fun way.
- Easy-to-follow instructions with step-by-step guidance.
- Includes all necessary materials for multiple experiments.
- Develops problem-solving skills and encourages curiosity.
CONS
- Some components may have a strong chemical odor.
- Supervision is recommended for younger children.
- The slime may require adjustments in consistency to achieve optimal texture.
Prepare for an exhilarating scientific adventure with the Steve Spangler Science Liquid Worms Experiment Kit! This comprehensive kit is designed to captivate young minds and immerse them in the wonders of polymer science. Through hands-on exploration, kids will discover the intriguing behavior of slime, a fascinating material that exhibits both liquid and solid properties.
Each kit includes various colored solutions and activators, enabling multiple experiments. Clear, easy-to-understand instructions guide the young scientists throughout the process, fostering their understanding of chemical reactions and the science behind polymers. As they mix and experiment, kids will observe the transformation of solutions into slimy worms, gaining insights into the molecular structure and elasticity of these unique materials. This kit不仅 is an engaging and fun way to learn about science but also stimulates creativity, problem-solving abilities, and a passion for scientific exploration.

PROS
- Provides an engaging and entertaining way for kids to learn about the science of polymers
- Comes with all the necessary materials to make your own string slime, allowing for hands-on experimentation
- Includes a detailed instruction guide that makes it easy for kids to follow and understand the scientific concepts behind the activity
CONS
- The slime may be messy to clean up, so it's recommended to use it on a surface that can be easily wiped down
- The kit includes a limited amount of slime powder, so you may need to purchase additional powder if you want to make a larger batch of slime
The Steve Spangler Science String Slime Starter Kit is a great way to introduce kids to the science of polymers. The kit includes everything you need to make your own string slime, including blue and yellow slime powder, a mixing bowl, a spoon, and a detailed instruction guide.
The instruction guide is easy to follow and provides a clear explanation of the scientific concepts behind the activity. Kids will learn about how polymers form and how they can be used to create different types of materials. The slime is also a lot of fun to play with, and it can be used to create a variety of different shapes and structures.

PROS
- Comprehensive kit with everything you need to raise earthworms.
- Educational and fun, teaching kids about worm habitats and life cycles.
CONS
- Requires some setup and maintenance to keep the habitat clean.
- May not be suitable for young children due to the delicate nature of the worms.
Journey into the fascinating world of worms with Fat Brain Toys' Worm Farm Liquid Science Kit! This comprehensive kit is an ideal choice for young scientists ages 6 and up, providing an immersive experience that teaches them about the biology and lifecycle of earthworms. With a clear plastic habitat, kids can observe worms' behavior and activities up close while maintaining a clean and contained environment.
The kit includes a detailed guide with instructions and fun facts, making it easy for kids to grasp the scientific concepts and engage with nature. It's a great tool for introducing composting and environmental responsibility. The hands-on nature of the kit fosters a love for science, encouraging exploration and discovery. Overall, Fat Brain Toys' Worm Farm Liquid Science Kit is an enriching and educational experience that combines science and fun in a captivating way.

PROS
- Engaging and interactive STEM project for kids ages 6 and up
- Helps children learn about chemistry and the properties of different materials
- Comes with all the materials needed to create string slime goo
- Easy-to-follow instructions make it perfect for home or classroom use
- A fun and educational way to explore science
CONS
- Adult supervision is recommended for younger children
- Some of the ingredients may be irritating to the skin or eyes
- The slime can be messy, so it's important to clean up afterwards
This STEM Science Kit is a great way to introduce kids to the wonderful world of science. With String Slime Goo, young scientists can learn about chemistry and the properties of different materials in a fun and engaging way. The kit comes with everything you need to create your own string slime goo, including a detailed instruction booklet that makes the process easy to follow.
Not only is this kit a great way to learn about science, but it's also a lot of fun. Kids will love mixing the ingredients together and watching their string slime goo come to life. Once they're done, they can play with their slime goo and explore its unique properties. This kit is a great way to encourage creativity and imagination, and it's also a great way to spend quality time with your kids.

PROS
- Captivating and educational experience for inquisitive young minds.
- Introduces STEM principles through engaging hands-on experiments.
- Easy-to-follow instructions and high-quality materials ensure a fun and productive learning journey.
CONS
- Supervision of younger children may be necessary during certain experiments.
- Some materials, such as vinegar and baking soda, may require additional purchase.
Unlock the world of science for your little explorers with the thrilling Test Tube Science Kits! Designed to spark curiosity and ignite a passion for exploration, this kit provides everything budding scientists need to conduct 15 captivating experiments. From creating their very own liquid worms to investigating chemical reactions, young minds will embark on a series of hands-on adventures that make learning an unforgettable experience.
With clear instructions and top-notch materials, these science kits provide a safe and engaging environment for children to experiment and discover. Whether they're unraveling the secrets of acids and bases or building a mini volcano, kids will delve into the fascinating realm of science, paving the way for a lifelong love of learning and exploration.

PROS
- Foster scientific curiosity and hands-on experimentation with liquid worm experiments.
- Develop fine motor skills and sensory awareness through tactile play.
- Includes a detailed instruction manual and necessary materials for guided learning.
CONS
- May require adult supervision for younger children.
- Could benefit from additional experiment variations or resources.
Unleash the wonders of science with the Crayola Liquid Science Kit for Kids! This educational toy transforms ordinary water into a captivating liquid medium, inviting young minds to embark on fascinating water experiments. At the heart of these experiments lies the intriguing concept of liquid worms, providing a unique way to explore scientific principles and cultivate a love of science.
Furthermore, the kit's interactive and engaging approach not only nurtures a thirst for knowledge but also enhances fine motor skills and sensory awareness. The hands-on, tactile nature of the experiments fosters a deep understanding of the underlying concepts. While targeted towards children, the kit's versatility and ease of use make it suitable for learners of all ages. Its fun and engaging nature makes it an excellent gift, providing endless hours of educational entertainment and inspiration.

PROS
- Engaging and educational experiment kit for kids and adults alike
- Demonstrates key principles of bacterial growth and reproduction
- Includes all necessary materials for conducting the experiment
CONS
- Additional supplies like a microscope or magnifying glass may be required
- Requires patience and careful observation over several days
Prepare to unravel the intriguing realm of microbiology with Steve Spangler's captivating Growing Bacteria Science Experiment Kit! This comprehensive kit empowers you to explore the fascinating world of bacteria, fostering an understanding of their growth and reproduction. Immerse yourself in the wonders of science as you witness firsthand the formation of 'liquid worms,' captivating stringy structures formed by the multiplication of bacteria. The kit provides an engaging and interactive learning experience, making it an ideal resource for classrooms, homeschooling, or anyone eager to unlock the secrets of the microbial world.
Steve Spangler's Growing Bacteria Science Experiment Kit is meticulously designed to ensure a successful experiment. The kit includes all the essential materials, including agar powder, nutrient broth, sterile petri dishes, and detailed instructions. Simply follow the clear guidelines, and you're well on your way to cultivating and observing your very own bacterial ecosystem. This kit not only provides hands-on experience but also encourages critical thinking and scientific inquiry, nurturing a deeper appreciation for the intricate workings of the natural world.

PROS
- Includes 25 exciting chemistry-based food experiments for yummy fun
- Make worms-shaped edible slime chocolates that are so delicious and gooey
- An excellent way to introduce kids to the wonders of food science in a fun and engaging way
- Perfect for young scientists between the ages of 8 and 12; makes a great gift for Christmas, Hanukkah, birthdays, summer camp, and more
CONS
- Close adult supervision is required, as the kit contains small parts and chemicals.
- Not suitable for children under 8 years of age.
Calling all budding scientists and candy lovers! Join Playz on an extraordinary edible adventure with our Liquid Worms Slime Candy Science Kit. This engaging kit is overflowing with 25 captivating experiments that transform science into an exciting culinary experience, introducing kids to the fascinating world of food chemistry.
The highlight of this kit is the creation of wiggly, edible slime chocolates shaped like worms. These delectable treats are not only visually appealing but also incredibly tasty, sure to ignite joy and amazement in young hearts. With easy-to-follow instructions and clear safety guidelines, young scientists can embark on this scientific escapade with confidence, guided by curious minds and a thirst for knowledge. Whether you're a parent looking to foster a love of science in your child or an educator seeking to make learning enjoyable, the Playz Liquid Worms Edible Slime Candy Science Kit is an exceptional choice. Get ready for an unforgettable journey where sugary delights meet scientific wonders, leaving a lasting impression on young minds.

PROS
- Engage kids in captivating science experiments with jumbo test tubes and liquid worms.
- Foster problem-solving and curiosity with numerous activities and tools.
- High-quality materials ensure durability and safety for young explorers.
CONS
- May require adult supervision for younger children.
- Liquid worms may leave some residue, necessitate careful cleanup.
Dive into the fascinating world of science with the Weewooday Liquid Worms Science Kit! This comprehensive set empowers kids to conduct exciting experiments, nurturing their curiosity and problem-solving skills. The kit features jumbo test tubes, liquid worms, droppers, and various tools, providing all the essentials for hours of scientific exploration.
.
The liquid worms add an interactive element that captivates young minds, while the durable materials ensure safety and longevity. The kit is designed to spark imagination and encourage kids to explore the wonders of science hands-on. Educators and parents alike will find this kit an invaluable resource for fostering a love of science in children.

PROS
- Observe live worms up close and learn about their life cycle.
- Comes with everything you need to create a thriving worm farm, including worms, soil, and a magnifying glass.
CONS
- DIY assembly is required
- May not be suitable for all ages
Get ready to embark on an exciting scientific adventure with this comprehensive liquid worms science kit. Perfect for budding biologists, this kit provides a hands-on opportunity to explore the fascinating world of worms and their role in our ecosystem. With live worms included, you can witness firsthand the life cycle of these incredible creatures.
But that's not all! The kit also includes everything you need to establish your own thriving worm farm, including soil, sand, and a magnifying glass for detailed observations. This is an excellent educational tool for classrooms or homeschooling environments, fostering curiosity and a deeper understanding of nature.
In this guide, we have curated the top liquid worms science kits that cater to diverse interests and ages. As your child embarks on this scientific adventure, they will gain a deeper understanding of worm behavior, anatomy, and the importance of these creatures in maintaining a healthy ecosystem. Through captivating experiments and engaging activities, these kits foster a love for learning and nurture future scientists.
Frequently Asked Questions
What are the benefits of using a liquid worms science kit?
Liquid worms science kits offer numerous benefits for kids, including fostering their curiosity, developing their observation skills, enhancing their understanding of worm biology, and encouraging a lifelong passion for science.
What age group is best suited for liquid worms science kits?
Liquid worms science kits are generally designed for children ages 6 and up, ensuring they have the maturity and cognitive abilities to fully engage with the experiments and activities.
How do liquid worms science kits contribute to a child's education?
These kits align with educational standards and provide hands-on learning experiences that complement classroom lessons, reinforcing scientific concepts and fostering a deeper understanding of the natural world.
What safety precautions should be taken when using liquid worms science kits?
Safety should always be a priority, especially when working with living organisms. Ensure children wear gloves and wash their hands thoroughly before and after handling the worms and materials.
Can liquid worms science kits be used in a homeschooling environment?
Absolutely! These kits are versatile and can be seamlessly incorporated into homeschooling curriculums, providing a practical and engaging way to explore science concepts and develop critical thinking skills.